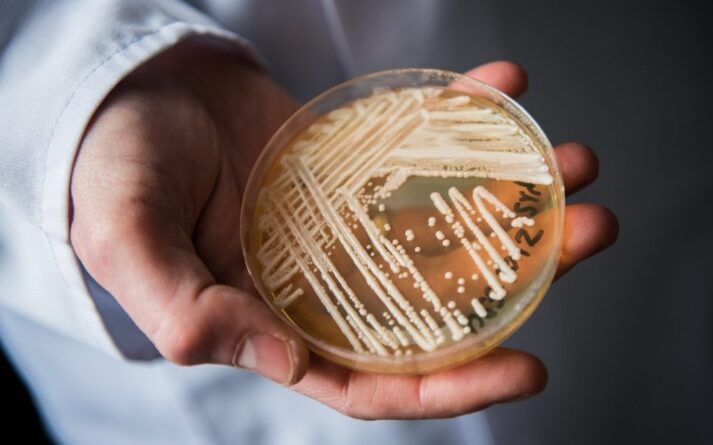

RN EM ALERTA: caso suspeito do fungo “assassino” Candida auris em hospital de Natal
Foto: Getty Images
O RN pode ter registrado o primeiro caso do fungo Candida auris, considerado de alto risco, em um paciente internado no Hospital Central Coronel Pedro Germano, o Hospital da PM, em Natal. A suspeita surgiu após exames iniciais feitos pelo Lacen no dia 20, mas a confirmação só virá com novo teste em laboratório de referência em São Paulo.
O paciente tem 58 anos, está isolado e recebe acompanhamento médico constante. A Sesap garante que todos os protocolos de segurança foram acionados para evitar a transmissão dentro da unidade, com vigilância reforçada das equipes de saúde.
Candida auris preocupa autoridades por ser resistente a vários antifúngicos e sobreviver por longos períodos em superfícies hospitalares, como leitos, equipamentos e móveis.
O fungo ataca principalmente pacientes com imunidade baixa, em especial em UTIs, e se espalha por contato direto com objetos contaminados ou entre pessoas no hospital. Fora desses ambientes, o risco para a população é baixo.
Primeiro registro no país foi em 2020
No Brasil, o primeiro registro foi em 2020, e surtos já ocorreram em estados como Bahia, Pernambuco, Rio de Janeiro, São Paulo e Minas Gerais, totalizando 114 casos confirmados, segundo a Anvisa.
Os sintomas podem se confundir com outras infecções hospitalares e incluem febre persistente, tontura, pressão alterada, falta de ar e aceleração dos batimentos cardíacos.
Fonte Blog do BG